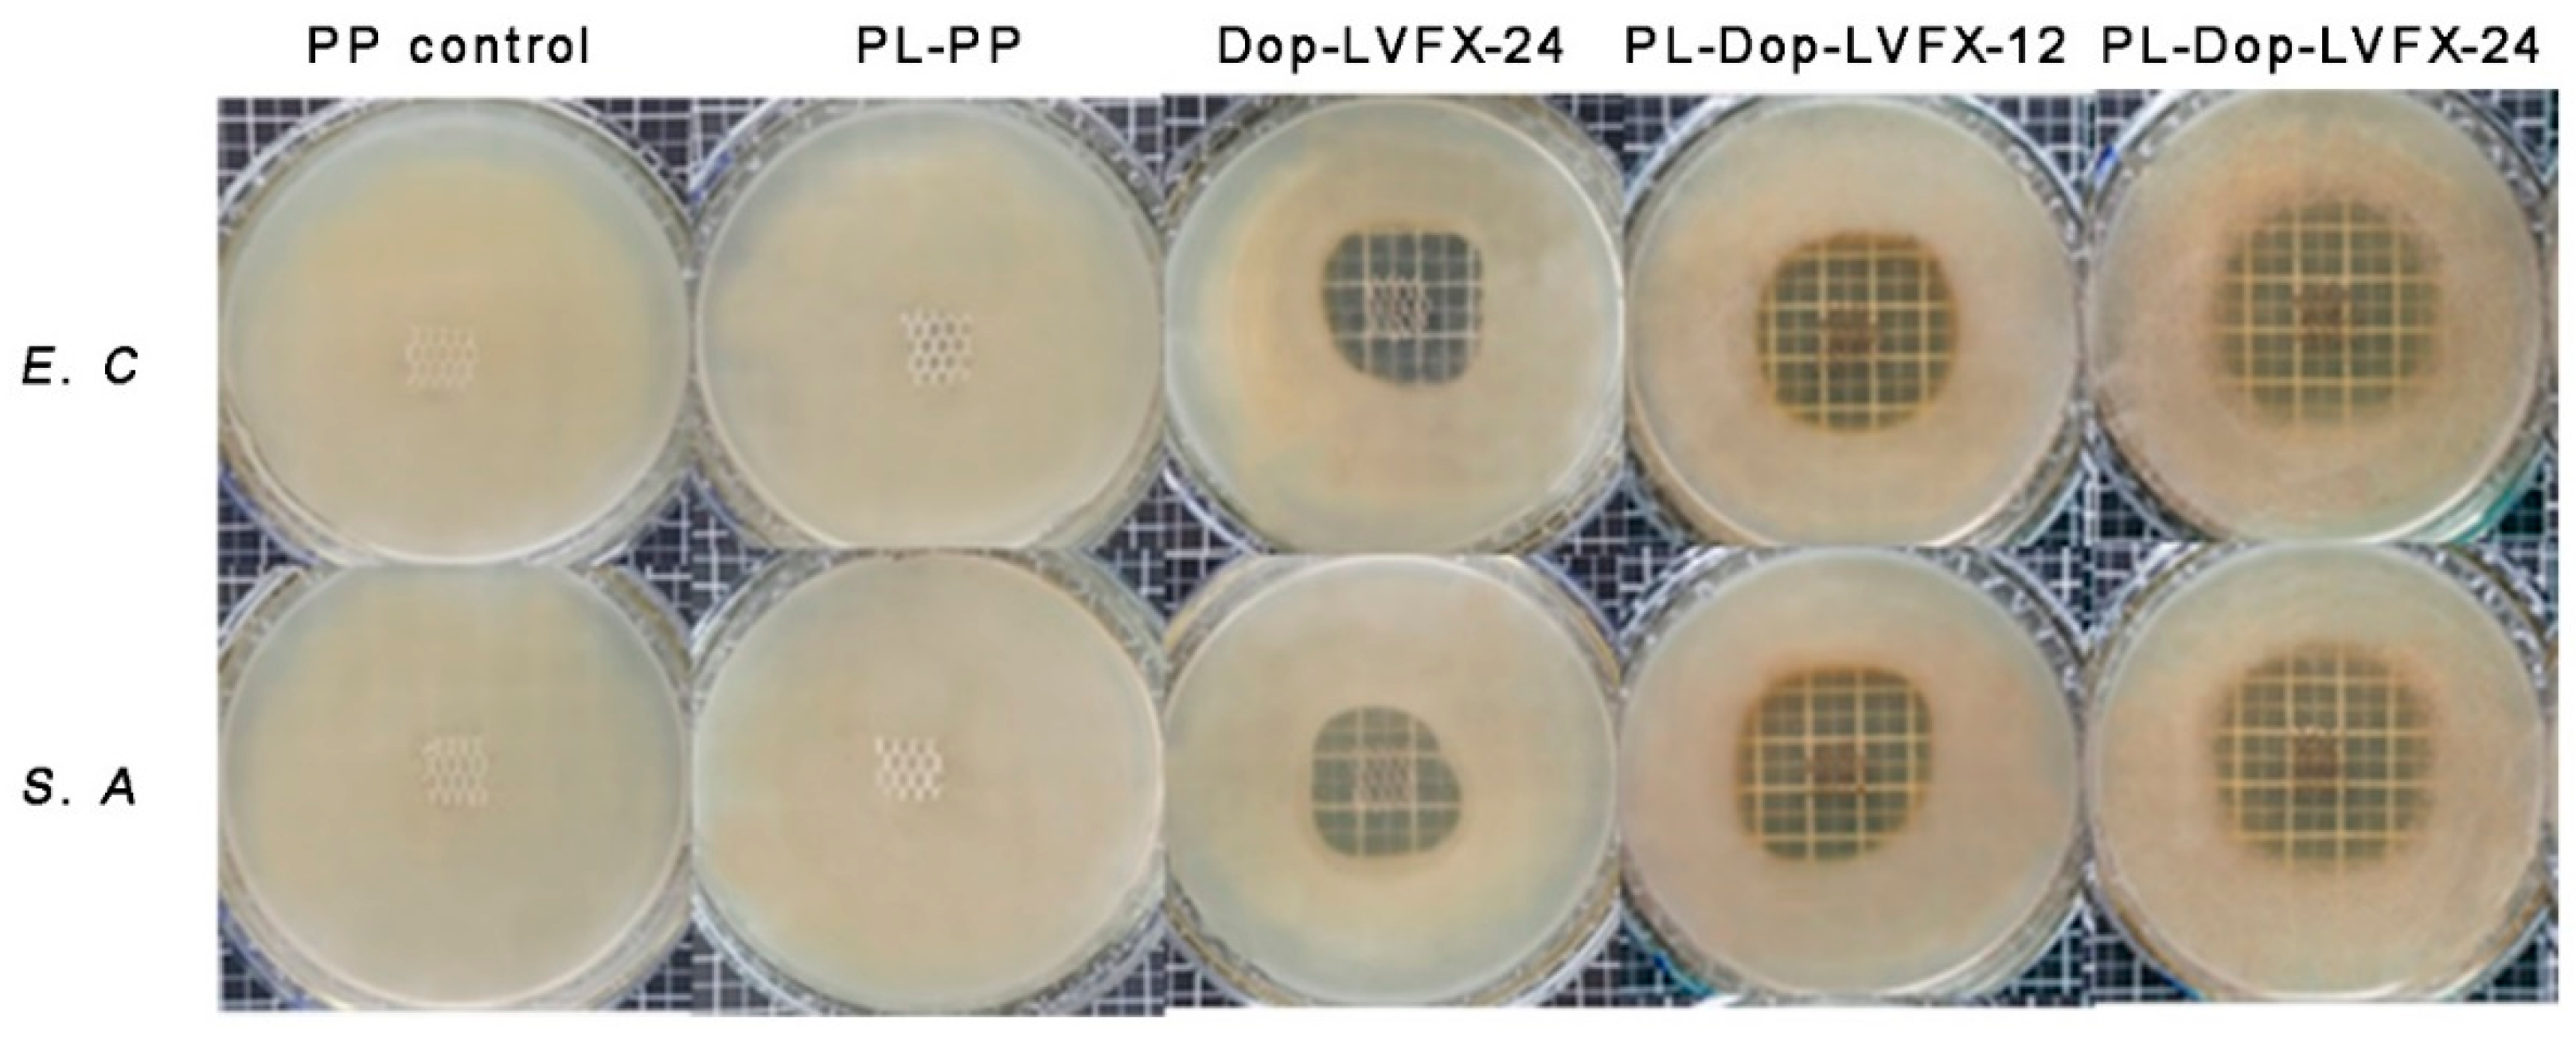
Coatings 09 00164 g007

Polydopamine-Inspired Surface Modification of Polypropylene Hernia Mesh Devices via Cold Oxygen Plasma: Antibacterial and Drug Release Properties
Abstract
:1. Introduction
2. Materials and Methods
2.1. Materials
2.2. Surface Functionalization of PP with Oxygen Plasma
2.3. Coating of Polydopamine (PDA) on PP Meshes
2.4. Loading and Release of Levofloxacin
2.5. Characterization of Modified PP Meshes
2.6. Antibacterial Properties
Qualitative Analysis
3. Results and Discussion
3.1. Polydopamine Coated and Levofloxacin Loaded
3.2. Surface Morphology of Modified PP Meshes
3.3. Chemical Characterization of Modified PP Meshes
3.4. Antibacterial Activity
3.5. Drug Release Profile of PDA Coated and Levofloxacin Loaded PP Meshes
4. Conclusions
Author Contributions
Funding
Acknowledgments
Conflicts of Interest
References
- Guillaume, O.; Perez-Tanoira, R.; Fortelny, R.; Redl, H.; Moriarty, T.F.; Richards, R.G.; Eglin, D.; Petter Puchner, A. Infections associated with mesh repairs of abdominal wall hernias: Are antimicrobial biomaterials the longed-for solution? Biomaterials 2018, 167, 15–31. [Google Scholar] [CrossRef] [PubMed]
- Greca, F.; Paula, J.; Biondo-Simões, M.; Costa, F.; Silva, A.; Time, S.; Mansur, A. The influence of differing pore sizes on the biocompatibility of two polypropylene meshes in the repair of abdominal defects. Hernia 2001, 5, 59–64. [Google Scholar] [PubMed]
- Hazebroek, E.J.; Ng, A.; Yong, D.H.; Berry, H.; Leibman, S.; Smith, G.S. Evaluation of lightweight titanium-coated polypropylene mesh (TiMesh) for laparoscopic repair of large hiatal hernias. Surg. Endosc. 2008, 22, 2428–2432. [Google Scholar] [CrossRef] [PubMed]
- Jerabek, J.; Novotny, T.; Vesely, K.; Cagas, J.; Jedlicka, V.; Vlcek, P.; Capov, I. Evaluation of three purely polypropylene meshes of different pore sizes in an onlay position in a New Zealand white rabbit model. Hernia 2014, 18, 855–864. [Google Scholar] [CrossRef] [PubMed]
- Kulaga, E.; Ploux, L.; Balan, L.; Schrodj, G.; Roucoules, V. Mechanically responsive antibacterial plasma polymer coatings for textile biomaterials. Plasma Process. Polym. 2014, 11, 63–79. [Google Scholar] [CrossRef]
- Knetsch, M.L.W.; Koole, L.H. New strategies in the development of antimicrobial coatings: The example of increasing usage of silver and silver nanoparticles. Polymers 2011, 3, 340–366. [Google Scholar] [CrossRef]
- Mazaki, T.; Mado, K.; Masuda, H.; Shiono, M.; Tochikura, N.; Kaburagi, M. A randomized trial of antibiotic prophylaxis for the prevention of surgical site infection after open mesh-plug hernia repair. Am. J. Surg. 2014, 207, 476–484. [Google Scholar] [CrossRef] [PubMed]
- Mazaki, T.; Mado, K.; Masuda, H.; Shiono, M. Antibiotic prophylaxis for the prevention of surgical site infection after tension-free hernia repair: A Bayesian and frequentist meta-analysis. J. Am. Coll. Surg. 2013, 217, 788–801. [Google Scholar] [CrossRef] [PubMed]
- Perez-Kohler, B.; Fernandez-Gutierrez, M.; Pascual, G.; Garcia-Moreno, F.; San Roman, J.; Bellon, J.M. In vitro assessment of an antibacterial quaternary ammonium-based polymer loaded with chlorhexidine for the coating of polypropylene prosthetic meshes. Hernia 2016, 20, 869–878. [Google Scholar] [CrossRef] [PubMed]
- Zhang, Z.; Tang, J.; Wang, H.; Xia, Q.; Xu, S.; Han, C.C. Controlled antibiotics release system through simple blended electrospun fibers for sustained antibacterial effects. ACS Appl. Mater. Interfaces 2015, 7, 26400–26404. [Google Scholar] [CrossRef] [PubMed]
- Sanbhal, N.; Miao, L.; Xu, R.; Khatri, A.; Wang, L. Physical structure and mechanical properties of knitted hernia mesh materials: A review. J. Ind. Text. 2017, 48, 333–360. [Google Scholar] [CrossRef]
- Muzio, G.; Miola, M.; Perero, S.; Oraldi, M.; Maggiora, M.; Ferraris, S.; Vernè, E.; Festa, V.; Festa, F.; Canuto, R.A.; et al. Polypropylene prostheses coated with silver nanoclusters/silica coating obtained by sputtering: Biocompatibility and antibacterial properties. Surf. Coat. Technol. 2017, 319, 326–334. [Google Scholar] [CrossRef] [Green Version]
- Labay, C.; Canal, J.M.; Modic, M.; Cvelbar, U.; Quiles, M.; Armengol, M.; Arbos, M.A.; Gil, F.J.; Canal, C. Antibiotic-loaded polypropylene surgical meshes with suitable biological behaviour by plasma functionalization and polymerization. Biomaterials 2015, 71, 132–144. [Google Scholar] [CrossRef] [PubMed]
- Nisticò, R.; Rosellini, A.; Rivolo, P.; Faga, M.G.; Lamberti, R.; Martorana, S.; Castellino, M.; Virga, A.; Mandracci, P.; Malandrino, M.; et al. Surface functionalisation of polypropylene hernia-repair meshes by RF-activated plasma polymerisation of acrylic acid and silver nanoparticles. Appl. Surf. Sci. 2015, 328, 287–295. [Google Scholar] [CrossRef]
- Nisticò, R.; Magnacca, G.; Faga, M.G.; Gautier, G.; D’Angelo, D.; Ciancio, E.; Lamberti, R.; Martorana, S. Effect of atmospheric oxidative plasma treatments on polypropylenic fibers surface: Characterization and reaction mechanisms. Appl. Surf. Sci. 2013, 279, 285–292. [Google Scholar] [CrossRef]
- Zhang, Z.; Zhang, T.; Li, J.; Ji, Z.; Zhou, H.; Zhou, X.; Gu, N. Preparation of poly(l-lactic acid)-modified polypropylene mesh and its antiadhesion in experimental abdominal wall defect repair. J. Biomed. Mater. Res. Part. B Appl. Biomater. 2014, 102, 12–21. [Google Scholar] [CrossRef] [PubMed]
- Sanbhal, N.; Mao, Y.; Sun, G.; Xu, R.F.; Zhang, Q.; Wang, L. Surface modification of polypropylene mesh devices with cyclodextrin via cold plasma for hernia repair: Characterization and antibacterial properties. Appl. Surf. Sci. 2018, 439, 749–759. [Google Scholar] [CrossRef]
- Jelil, R.A. A review of low-temperature plasma treatment of textile materials. J. Mater. Sci. 2015, 50, 5913–5943. [Google Scholar] [CrossRef]
- Lai, J.; Sunderland, B.; Xue, J.; Yan, S.; Zhao, W.; Folkard, M.; Michael, B.D.; Wang, Y. Study on hydrophilicity of polymer surfaces improved by plasma treatment. Appl. Surf. Sci. 2006, 252, 3375–3379. [Google Scholar] [CrossRef]
- Khelifa, F.; Ershov, S.; Habibi, Y.; Snyders, R.; Dubois, P. Free-radical-induced grafting from plasma polymer surfaces. Chem. Rev. 2016, 116, 3975–4005. [Google Scholar] [CrossRef] [PubMed]
- Patel, H.; Ostergard, D.R.; Sternschuss, G. Polypropylene mesh and the host response. Int. Urogynecol. J. 2012, 23, 669–679. [Google Scholar] [CrossRef] [PubMed]
- Perez-Kohler, B.; Bayon, Y.; Bellon, J.M. Mesh infection and hernia repair: A review. Surg. Infect. 2016, 17, 124–137. [Google Scholar] [CrossRef] [PubMed]
- Liu, Y.; Fang, Y.; Qian, J.; Liu, Z.; Yang, B.; Wang, X. Bio-inspired polydopamine functionalization of carbon fiber for improving the interfacial adhesion of polypropylene composites. RSC Adv. 2015, 5, 107652–107661. [Google Scholar] [CrossRef]
- Ngo, T.H.A.; Nguyen, D.T.; Do, K.D.; Nguyen, T.T.M.; Mori, S.; Tran, D.T. Surface modification of polyamide thin film composite membrane by coating of titanium dioxide nanoparticles. J. Sci. Adv. Mater. Devices 2016, 1, 468–475. [Google Scholar] [CrossRef] [Green Version]
- Ying, T.; Guo-Xin, T.; Cheng-Yun, N.; Xi-Cang, R.; Yu, Z.; Lei, Z. Bioinspired polydopamine functionalization of titanium surface for silvernanoparticles immobilization with antibacterial property. J. Inorg. Mater. 2014, 29, 1320–1326. [Google Scholar] [CrossRef]
- Zhang, R.X.; Breaken, L.; Liu, T.Y.; Luis, P.; Wang, X.L.; Van der Bruggen, B. Remarkable anti-fouling performance of TiO2-modified TFC membranes with mussel-inspired polydopamine binding. Appl. Sci. 2017, 7, 81. [Google Scholar] [CrossRef]
- Sanbhal, N.; Mao, Y.; Sun, G.; Li, Y.; Peerzada, M.; Wang, L. Preparation and characterization of antibacterial polypropylene meshes with covalently incorporated β-cyclodextrins and captured antimicrobial agent for Hernia repair. Polymers 2018, 10, 58. [Google Scholar] [CrossRef]
- Vishnuvarthanan, M.; Rajeswari, N. Effect of mechanical, barrier and adhesion properties on oxygen plasma surface modified PP. Innov. Food Sci. Emerg. Technol. 2015, 30, 119–126. [Google Scholar] [CrossRef]
- Fauland, G.; Constantin, F.; Gaffar, H.; Bechtold, T. Production scale plasma modification of polypropylene baselayer for improved water management properties. J. Appl. Polym. Sci. 2015, 132, 41294. [Google Scholar] [CrossRef]
- Sorrentino, L.; Carrino, L.; Napolitano, G. Oxygen cold plasma treatment on polypropylene: Influence of process parameters on surface wettability. Surf. Eng. 2013, 23, 247–252. [Google Scholar] [CrossRef]
- Sanbhal, N.; Saitter, X.; Peerzada, M.; Habboush, A.; Wang, F.; Wang, L. One-step surface functionalized hydrophilic polypropylene meshes for hernia repair using bio-inspired polydopamine. Fibres 2019, 7, 6. [Google Scholar] [CrossRef]
- Sanbhal, N.; Saitaer, X.; Li, Y.; Mao, Y.; Zou, T.; Sun, G.; Wang, L. Controlled levofloxacin release and antibacterial properties of β-cyclodextrins-grafted polypropylene mesh devices for hernia repair. Polymers 2018, 10, 493. [Google Scholar] [CrossRef]
- Laurent, T.; Kacem, I.; Blanchemain, N.; Cazaux, F.; Neut, C.; Hildebrand, H.F.; Martel, B. Cyclodextrin and maltodextrin finishing of a polypropylene abdominal wall implant for the prolonged delivery of ciprofloxacin. Acta Biomater. 2011, 7, 3141–3149. [Google Scholar] [CrossRef] [PubMed]
- Otero-Espinar, F.J.; Torres-Labandeira, J.J.; Alvarez-Lorenzo, C.; Blanco-Méndez, J. Cyclodextrins in drug delivery systems. J. Drug Deliv. Sci. Technol. 2010, 20, 289–301. [Google Scholar] [CrossRef]
- Thatiparti, T.R.; Shoffstall, A.J.; von Recum, H.A. Cyclodextrin-based device coatings for affinity-based release of antibiotics. Biomaterials 2010, 31, 2335–2347. [Google Scholar] [CrossRef] [PubMed]
- Avetta, P.; Nisticò, R.; Faga, M.G.; D’Angelo, D.; Boot, E.A.; Lamberti, R.; Martorana, S.; Calza, P.; Fabbri, D.; Magnacca, G. Hernia-repair prosthetic devices functionalised with chitosan and ciprofloxacin coating: Controlled release and antibacterial activity. J. Mater. Chem. B 2014, 2, 5287–5294. [Google Scholar] [CrossRef]
- Nisticò, R.; Faga, M.G.; Gautier, G.; Magnacca, G.; D’Angelo, D.; Ciancio, E.; Piacenza, G.; Lamberti, R.; Martorana, S. Physico-chemical characterization of functionalized polypropylenic fibers for prosthetic applications. Appl. Surf. Sci. 2012, 258, 7889–7896. [Google Scholar] [CrossRef]
- Erdas, E.; Medas, F.; Pisano, G.; Nicolosi, A.; Calo, P.G. Antibiotic prophylaxis for open mesh repair of groin hernia: Systematic review and meta-analysis. Hernia 2016, 20, 765–776. [Google Scholar] [CrossRef] [PubMed]

| Time (h) | Dop-LVFX-24 (%) | PL-Dop-LVFX-12 (%) | PL-Dop-LVFX-24 (%) |
|---|---|---|---|
| 0 | 0 | 0 | 0 |
| 1 | 56 ± 1.3 | 47 ± 1.5 | 41 ± 1.6 |
| 3 | 80 ± 1.2 | 65 ± 1.3 | 61 ± 1.5 |
| 6 | 100 ± 1.5 | 79 ± 1.3 | 72 ± 1.3 |
| 12 | – | 92 ± 1.5 | 86 ± 1.4 |
| 24 | – | 99 ± 1.0 | 93 ± 1.6 |
© 2019 by the authors. Licensee MDPI, Basel, Switzerland. This article is an open access article distributed under the terms and conditions of the Creative Commons Attribution (CC BY) license (http://creativecommons.org/licenses/by/4.0/).
Share and Cite
Saitaer, X.; Sanbhal, N.; Qiao, Y.; Li, Y.; Gao, J.; Brochu, G.; Guidoin, R.; Khatri, A.; Wang, L. Polydopamine-Inspired Surface Modification of Polypropylene Hernia Mesh Devices via Cold Oxygen Plasma: Antibacterial and Drug Release Properties. Coatings 2019, 9, 164. https://doi.org/10.3390/coatings9030164
Saitaer X, Sanbhal N, Qiao Y, Li Y, Gao J, Brochu G, Guidoin R, Khatri A, Wang L. Polydopamine-Inspired Surface Modification of Polypropylene Hernia Mesh Devices via Cold Oxygen Plasma: Antibacterial and Drug Release Properties. Coatings. 2019; 9(3):164. https://doi.org/10.3390/coatings9030164
Chicago/Turabian StyleSaitaer, Xiakeer, Noor Sanbhal, Yansha Qiao, Yan Li, Jing Gao, Gaetan Brochu, Robert Guidoin, Awais Khatri, and Lu Wang. 2019. "Polydopamine-Inspired Surface Modification of Polypropylene Hernia Mesh Devices via Cold Oxygen Plasma: Antibacterial and Drug Release Properties" Coatings 9, no. 3: 164. https://doi.org/10.3390/coatings9030164






